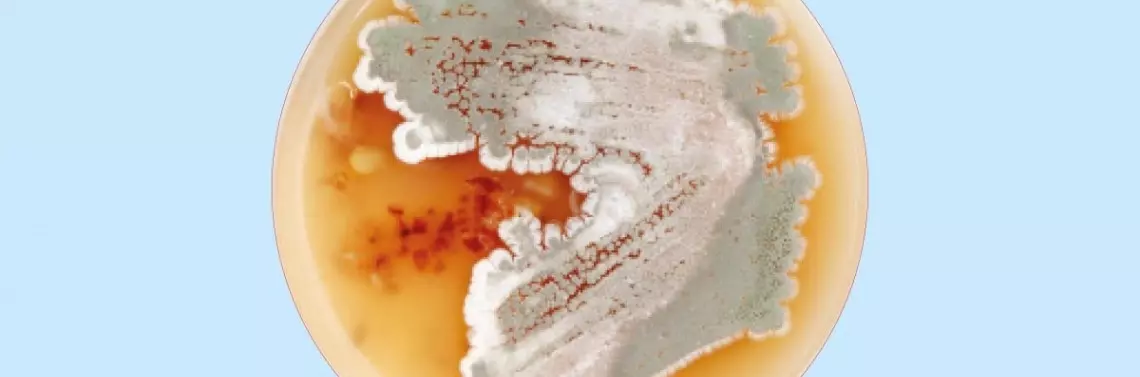

Promieniowce (Actinomycetes) mają budowę prokariotyczną, ale morfologią, cyklem rozwojowym i sposobem rozmnażania przypominają eukariotyczne grzyby strzępkowe. Należą do grupy bakterii Gram-dodatnich. Strzępki promieniowców mają średnicę około 1 µm i są mniej zróżnicowane morfologicznie niż strzępki grzybów. Wzrost kolonii promieniowców polega na rozwoju najpierw delikatnej i luźnej siatki strzępek grzybni substratowej (podstawowej, wegetatywnej) wnikających w głąb podłoża, skąd pobierają składniki odżywcze. W późniejszym etapie powstaje grzybnia generatywna (wtórna, powietrzna), tworząc górną, wypiętrzoną, bardzo zwartą część kolonii. Rozwój grzybni generatywnej kończy się sporulacją (zarodnikowaniem). Dojrzałe spory mają kształt elipsoidalny lub kulisty, ciemnieją i występują w łańcuszkach, które łatwo się rozpadają (rys. 1). Promieniowce są bakteriami chemoorganotroficznymi tworzącymi strzępki często rozgałęzione, a czasami w formie ściśle utkanej struktury. W porównaniu do innych bakterii charakteryzują się dużym genomem, a także wysoką zawartością G + C w DNA.
POLECAMY
Promieniowce w glebach
Ważną grupą bakterii występującą w glebach są promieniowce (Actinobacteria). Odgrywają istotną rolę w użyźnianiu i mineralizacji gleb oraz w degradacji związków trudno rozkładalny...
Pozostałe 90% treści dostępne jest tylko dla Prenumeratorów
- 6 wydań czasopisma "Biologia w Szkole"
- Dostęp do wszystkich archiwalnych artykułów w wersji online
- ...i wiele więcej!